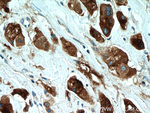
GCDFP-15/PIP Antibody in Immunohistochemistry (Paraffin) (IHC (P))
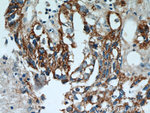
GCDFP-15/PIP Antibody in Immunohistochemistry (Paraffin) (IHC (P))
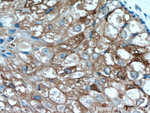
GCDFP-15/PIP Antibody in Immunohistochemistry (Paraffin) (IHC (P))

Search
Proteintech
GCDFP-15/PIP Polyclonal Antibody
{{$productOrderCtrl.translations['antibody.pdp.commerceCard.promotion.promotions']}}
{{$productOrderCtrl.translations['antibody.pdp.commerceCard.promotion.viewpromo']}}
{{$productOrderCtrl.translations['antibody.pdp.commerceCard.promotion.promocode']}}: {{promo.promoCode}} {{promo.promoTitle}} {{promo.promoDescription}}. {{$productOrderCtrl.translations['antibody.pdp.commerceCard.promotion.learnmore']}}
产品信息
16068-1-AP
种属反应
宿主/亚型
分类
类型
抗原
偶联物
形式
浓度
规格
纯化类型
保存液
内含物
保存条件
运输条件
产品详细信息
Immunogen sequence: AQDNTRKII IKNFDIPKSV RPNDEVTAVL AVQTELKECM VVKTYLISSI PLQGAFNYKY TACLCDDNPK TFYWDFYTNR TVQIAAVVDV IRELGICPDD AAVIPIKNNR FYTIEILKVE (28-146 aa encoded by BC010950)
靶标信息
Gross cystic disease of the breast is benign premenopausal disorder in which cysts are a predominant pathological lesion. These cysts appear to be formed from excessive apocrine cystic secretions. This fluid is composed of several glycoproteins including a unique 15kDa monomer protein, Gross Cystic Disease Fluid Protein-15 (GCDFP15). Cytosolic analysis of normal tissue specimens from all major organs has demonstrated GCDFP15 in apocrine epithelia, lacrimal, ceruminous and Moll's glands and in numerous serous cells of the submandibular, tracheal, bronchial, sublingual and minor salivary glands. GCDFP15 and prostate specific antigen are co-expressed in androgen receptor-positive breast tumours.
仅用于科研。不用于诊断过程。未经明确授权不得转售。
篇参考文献 (0)
生物信息学
蛋白别名: apocrine; gcdfp 15; GCDFP-15; gp17; Gross cystic disease fluid protein 15; HGNC:8993; Prolactin-induced protein; Prolactin-inducible protein; SABP; Secretory actin-binding protein; unnamed protein product
基因别名: BRST-2; GCDFP-15; GCDFP15; GPIP4; PIP
UniProt ID: (Human) P12273
Entrez Gene ID: (Human) 5304